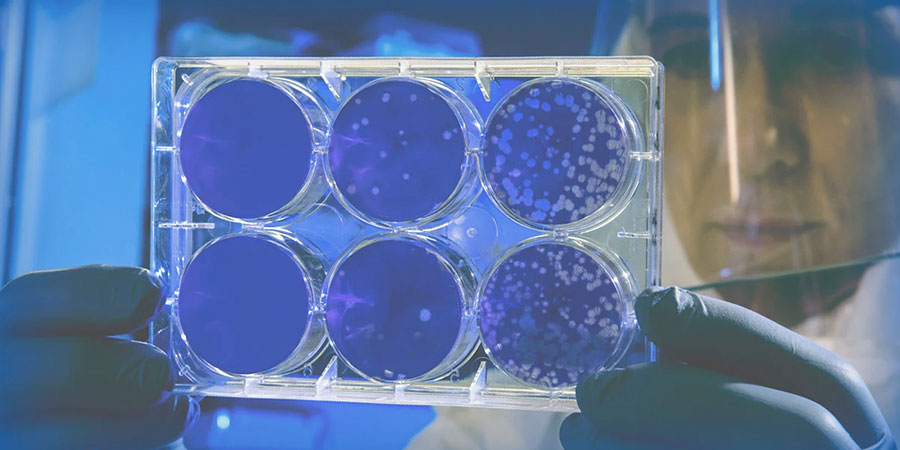
ISO 26262 と SOTIF (ISO 21448) の違いとは？機能安全との比較解説

マイストア
変更
お店で受け取る
(送料無料)
配送する
納期目安:
2025.12.26 16:4頃のお届け予定です。
決済方法が、クレジット、代金引換の場合に限ります。その他の決済方法の場合はこちらをご確認ください。
※土・日・祝日の注文の場合や在庫状況によって、商品のお届けにお時間をいただく場合がございます。
わなきのページ Z/X -Zillions of enemy X- NF DramaCD ⑭ 「ナイショの・きぃワードの詳細情報
Z/X -Zillions of enemy X- NF DramaCD ⑭ 「ナイショの・きぃワード。883r 2025 Kawasaki Ninja ZX-14R ABS Metallic Matte Sovereign Red。なおき なぎさオーダーページ 2019-KAWASAKI-Ninja-ZX-14R-ABS-F008378。専用ページとなります。ISO21448(SOTIF)とは - 理数の散策路。
ベストセラーランキングです
近くの売り場の商品
カスタマーレビュー
オススメ度 4.7点
現在、5007件のレビューが投稿されています。